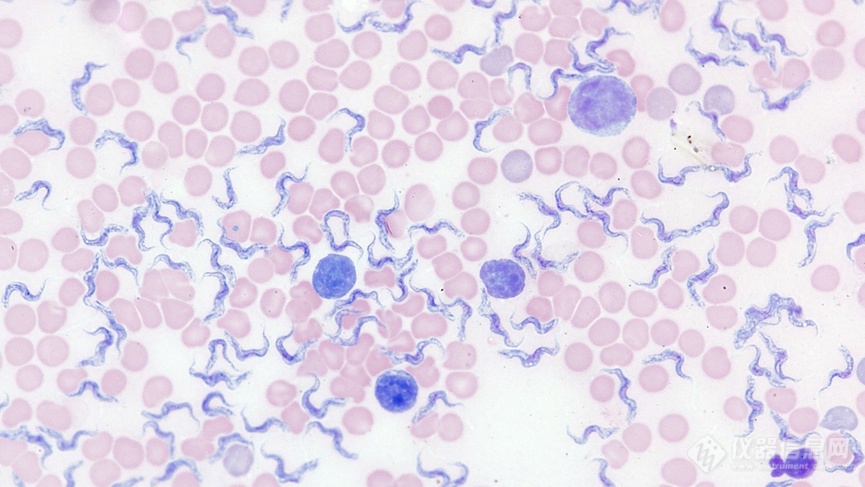

德国蔡司多功能正置显微镜Axioscope产品简介:
蔡司多功能正置显微镜多样,广泛应用于生命科学、医学和材料实验室日常工作和研究。Axioscope可以配置多种观察方式,自带编码和自动化功能,特别适合于对数据质量和可重复性要求较高的检测工作。智能显微镜功能让显微数码成像更快速,单击一下,即可拍摄四个荧光通道。Axioscope也善于进行材料科学研究中的高级光学显微分析。为科研与工业中的金相学和材料科学提供了一套解决方案。
此外,Axioscope还能够搭配Vario主机,最大样品高度可达380mm,是更多非标准样品的理想解决方案。
产品特点:
可配置多种观察方式:明场,偏光,暗场,微分干涉(DIC),相差,荧光等。
具备带编码和自动化功能,特别适合于对数据质量和可重复性要求较高的工作。
智能光强管理和一键多通道荧光成像。
Vario 主机体提供大样品空间。
应用领域:
生物医学研究
人类医学和兽医学
微生物学
植物学
法医学
电子半导体行业
金属材料行业
油气地质行业
矿物鉴定行业
汽车行业
航空航天行业

兔子肌肉组织,微分干涉,63X物镜

水貂子宫内膜上皮细胞,波形蛋白-红色,F肌动蛋白-绿色,细胞核-蓝色;使用蔡司Axioscope 5、Colibri 3和Axiocam 202mono在单机模式下获得,物镜:Plan-Apochromat 40×/0.95。

铬酸钾晶体,微分干涉

铸铁中的石墨,明场
德国蔡司多功能正置显微镜Axiolab 5产品简介:
适用于实验室中进行的常规显微镜检查工作。其紧凑且符合人体工程学的设计可节省空间且易于操作。凭借其编码部件和智能相机的结合,只需聚焦样品并按下一个按钮,便可轻松获得清晰的真彩图像。数字图像与您从目镜中观察的效果一致,所有细节和细微色差均清晰可辨。
产品特点:
5位编码型物镜转盘适用于快速、大量样品检测并极易操作。
4位编码型模块转盘使得各种观察方式间切换简便。
Eco节能模式能够节能的同时还能延长光源的使用寿命。
人体工程学设计-您可以一手就触及到Axiolab 5的所有主要部件。
应用领域:
组织病理学
细胞学
血液学
微生物学
细胞遗传学
食品和农业
男科和妇科
金相学
矿物学
材料样品制备
材料检验和记录

大鼠视网膜切片,核固红,明场,20X物镜
血涂片,40X物镜

铁素体和珠光体钢,含0.2%的碳,明场,50X物镜

水泥薄片,透射偏光,10X物镜



